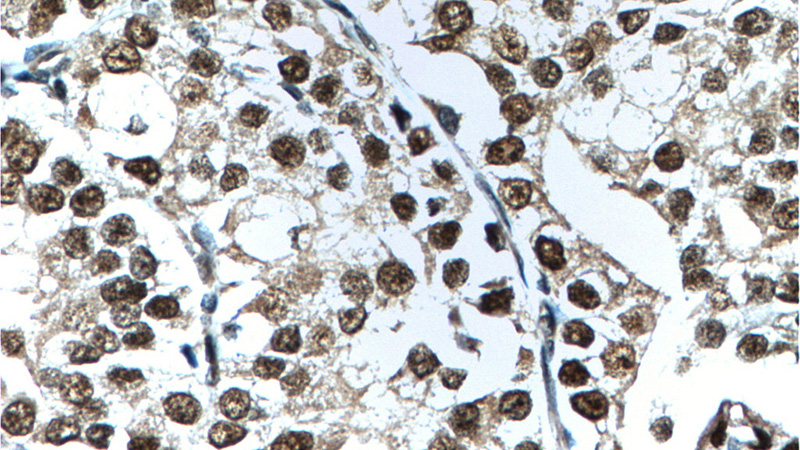
Immunohistochemistry of paraffin-embedded human prostate cancer tissue slide using Catalog No:108048(AR Antibody) at dilution of 1:200 (under 40x lens). heat mediated antigen retrieved with Tris-EDTA buffer(pH9).

-
Product Name
androgen receptor antibody
- Documents
-
Description
androgen receptor Rabbit Polyclonal antibody. Positive IHC detected in human prostate cancer tissue, mouse ovary tissue. Positive WB detected in PC-3 cells, HepG2 cells, LNCaP cells, MCF7 cells, mouse heart tissue, NIH/3T3 cells. Observed molecular weight by Western-blot: 71 kDa,100-110 kDa
-
Tested applications
ELISA, WB, IHC
-
Species reactivity
Human,Mouse,Rat; other species not tested.
-
Alternative names
AIS antibody; androgen receptor antibody; DHTR antibody; Dihydrotestosterone receptor antibody; HUMARA antibody; HYSP1 antibody; NR3C4 antibody; SBMA antibody; SMAX1 antibody; TFM antibody
-
Isotype
Rabbit IgG
-
Preparation
This antibody was obtained by immunization of androgen receptor recombinant protein (Accession Number: NM_000044). Purification method: Antigen affinity purified.
-
Clonality
Polyclonal
-
Formulation
PBS with 0.02% sodium azide and 50% glycerol pH 7.3.
-
Storage instructions
Store at -20℃. DO NOT ALIQUOT
-
Applications
Recommended Dilution:
WB: 1:500-1:5000
IHC: 1:20-1:200
-
Validations

PC-3 cells were subjected to SDS PAGE followed by western blot with Catalog No:108048(AR antibody) at dilution of 1:1000
Immunohistochemistry of paraffin-embedded human prostate cancer tissue slide using Catalog No:108048(AR Antibody) at dilution of 1:200 (under 40x lens). heat mediated antigen retrieved with Tris-EDTA buffer(pH9).
-
Background
AR, also named as DHTR and NR3C4, belongs to the nuclear hormone receptor family and NR3 subfamily. AR is a ligand-activated transcription factors that regulate eukaryotic gene expression and affect cellular proliferation and differentiation in target tissues. Transcription factor activity is modulated by bound coactivator and corepressor proteins. AR is activated, but not phosphorylated, by HIPK3. Defects in AR are the cause of androgen insensitivity syndrome (AIS), previously known as testicular feminization syndrome (TFM), which is an X-linked recessive form of pseudohermaphroditism due end-organ resistance to androgen. Defects in AR are the cause of spinal and bulbar muscular atrophy X-linked type 1 (SMAX1) which also known as Kennedy disease. Defects in AR may play a role in metastatic prostate cancer. Defects in AR are the cause of androgen insensitivity syndrome partial (PAIS) which also known as Reifenstein syndrome. This antibody is a rabbit polyclonal antibody raised against residues near the N terminus of human AR.
Related Products / Services
Please note: All products are "FOR RESEARCH USE ONLY AND ARE NOT INTENDED FOR DIAGNOSTIC OR THERAPEUTIC USE"
